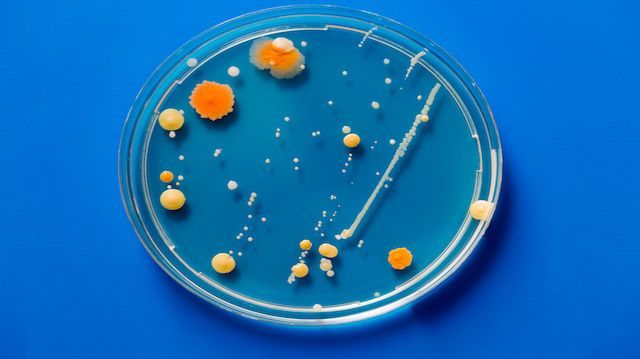

Multistate food poisoning outbreaks seem to be more common these days — it feels like we’re always reporting on some new E. coli outbreak. According to the Centers for Disease Control and Prevention (CDC), multistate outbreaks account for over half of the deaths caused by foodborne illnesses each year, and 91 percent of multistate outbreaks are due to just three germs: Salmonella, E. coli and Listeria.
By analyzing data from the years 2010 through 2014, the CDC found that 56 percent of all deaths from foodborne outbreaks come from the aforementioned bacteria. What’s more, multistate outbreaks are more difficult to track than local outbreaks for food poisoning. That’s because the food is already contaminated before it makes it to grocery stores or restaurant kitchens. No amount of proper storage and food safety at the point of sale can prevent the illness, and contaminated food typically ships to various locations at once.
In its recent report titled “Safer Food Saves Lives,” the CDC found, “Investigating these outbreaks often reveals problems on the farm, in processing or in distribution that resulted in contaminated food.” Salmonella, E. coli and Listeria present a number of concerns for people — including the risk of death — which makes the CDC’s report even more concerning. Here’s what you need to know about the big three: Salmonella, E. coli and Listeria.
Salmonella
According to the CDC, there are several different types of Salmonella, and some are more common during certain times of the year. However, regardless of the type of Salmonella — or the season — children under the age of five, older people, and individuals with weakened immune systems are at most risk for severe complications.
Complications from Salmonella can include diarrhea and several months of interrupted or irregular bowel habits. A small percentage of patients diagnosed with Salmonella develop reactive arthritis, or pain in their joints, which can last up to several years, leading to a chronic condition. Salmonella is responsible for about 1.2 million illnesses and 450 deaths per year in the U.S.
E. coli
E. coli is short for Escherichia coli, and it’s frequently in the news. The bacteria are found not only in the environment but also in the intestines of animals and people. Most strains of the bacteria are pretty harmless, but the strains that can make you sick can cause illnesses like pneumonia, urinary tract infections and more.
Infected people experience severe stomach cramps, vomiting and diarrhea. Sometimes patients experience a minor fever, but most people recover within about a week or so. No one is immune to E. coli, but the very young and the elderly are at most risk of complications. According to the CDC, “Some infections are very mild, but others are severe or even life-threatening.”
Listeria
Listeria causes about 1,600 illnesses in the United States each year, and the bacteria is the third leading cause of death from foodborne illnesses. What makes it so scary is, according to the CDC, “At least 90 percent of people who get Listeria infections are either pregnant women and their newborns, people 65 or older, or people with weakened immune systems.” In fact, the CDC states that pregnant women are “10 percent more likely” to contract a Listeria infection, and it can lead to preterm labor, fetal loss, or illness or death of a newborn baby.
Sources of Listeria can include uncooked vegetables and meat, raw milk and cheese, as well as cooked or processed cheese, smoked seafood and meat. Listeria is particularly gross because it can live for years in a food processing plant, and can even grow and multiply in cold environments like a refrigerator, where other bacteria cannot.
Protect yourself
Although multistate outbreaks are scary, there are a few things that you can do to protect yourself from food poisoning.
- Eat pasteurized meat and dairy products.
- Use a thermometer to check the temperature of the food you’re preparing at home.
- Follow all preparation instructions, especially for raw meat and shellfish.
- Avoid consuming undercooked meat or eggs at a restaurant.
- Wash your hands and all surfaces when preparing food.
- Cook foods until they are “steaming hot,” especially ready-to-eat meats.
Be sure to also check back here, where we’ll keep you updated on the latest multistate outbreaks. We aren’t defenseless when it comes to Salmonella, E. coli and Listeria outbreaks, and taking some responsibility for our food choices goes a long way toward prevention.
Have you ever become sick with one of the big three bugs?
—Megan Winkler
Megan Winkler is an author, historian, Neurosculpting® meditation coach, certified nutritional consultant and DIY diva. When she’s not writing or teaching a class, Megan can be found in the water, on a yoga mat, learning a new instrument or singing karaoke. Her passion for a healthy mind-body-spirit relationship motivates her to explore all the natural world has to offer.
Sources:
http://www.cdc.gov/vitalsigns/foodsafety-2015/index.html
http://www.cdc.gov/salmonella/general
http://www.cdc.gov/ecoli/general/index.html#what-are-shiga-toxin
http://www.cdc.gov/listeria/sources.html
http://www.medicaldaily.com/just-3-germs-cause-91-all-multiple-state-food-poisoning-outbreaks-and-half-deaths-cdc-360234
http://www.webmd.com/food-recipes/food-poisoning/preventing-food-poisoning
